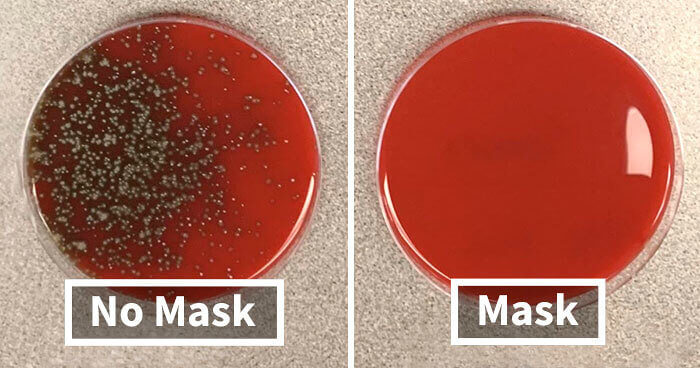
Regarde Ce Test De La Covid Pour Le Port D'un Masque Par Rapport À L'absence De Masque

This article was originally published on WackoJaco
La Différence Que Fait Un An Dans La Vie D'un Chiot Golden Retriever
Les chiots nous offrent du bonheur à l'état pur. Un chiot Golden Retriever, en particulier, offre des câlins de première qualité, c'est évident. Mais combien de temps ces adorables toutous restent-ils petits ?
Il s'avère qu'ils deviennent des adultes beaucoup trop rapidement. En moins d'un an, un chiot énergique se transforme en un adulte beau et loyal envers son maître. Regarde juste sa transformation en moins de 12 mois !
Voici La Tomate Moderne Et La Variété Existante Il y A 150 Ans
Les tomates que nous avons aujourd'hui ne ressemblent en rien à celles que la nature nous avait données. Elle a beaucoup changé pour s'adapter aux gouts des consommateurs ! On est certainement plusieurs curieux à se demander à quoi ressemblaient les aliments avant l'intervention de l'homme.
Lors de fouilles archéologiques dans une vielle ferme, une réserve de graines a été découverte. Pourquoi ne pas les planter pour voir ce qu'elles cachaient ? Quelqu'un a mis cette idée à exécution et voici le résultat. Elle n'est pas aussi photogénique que les variétés modernes, mais c'est bien une tomate. On dit qu'il ne faut pas juger un livre à sa couverture !
Le Moment Où L'homme Le Plus Grand Et Le Plus Petit Du Monde Se Sont Rencontrés
La plupart des gens se situent dans une fourchette normale de taille, même si de temps en temps, nous sommes complexés par celle-ci. Les véritables exceptions sont rares. Il était une fois la rencontre entre l'homme le plus grand et le plus petit de la terre. La comparaison côte à côte est tout à fait étonnante !
He Pingping mesure 73 centimètres et nous vient de Chine. Sultan Kösen c'est tout le contraire avec ses 2,51 m. C'est un agriculteur originaire de Turquie. En somme, un contraste incroyable !
Le Mannequinat, C'est Dans Leur Sang, Apparemment
On dit que la pomme ne tombe pas loin de l'arbre. Ce proverbe n'a jamais été aussi véridique lorsqu'il s'agit du mannequin Kaia Gerber et de sa célèbre maman. Le mannequin Cindy Crawford, sur la photo de droite, a vraiment créé une mini-réplique d'elle-même, comme tout le monde peut le voir !
Il est indéniable que Kaia a eu un mentor incroyable pour l'aider à apprendre les ficelles du métier. Mais avec un tel physique, il est difficile d'imaginer que les designers ne l'auraient pas remarquée de toute façon. Kaia a défilé pour les plus grands, de Tom Ford à Prada en passant par Alexander Wang. S'ils ont aimé Cindy, ils étaient destinés à aimer son double !
Cette Comparaison Effrayante Des Pattes D'un T-rex Et D'un Émeu Soulève Bien Des Questions
La théorie selon laquelle les oiseaux ont évolué à partir des dinosaures est bien ancrée dans l'esprit des gens désormais. Même si cela semble tiré par les cheveux, ou même carrément bizarre, les paléontologues ont bien développé et expliqué leur théorie. En regardant ce gros plan de la patte d'un émeu et de celle d'un dinosaure, on peut se forger notre propre opinion.
Apparemment, le tyrannosaure, le fameux prédateur aux dents acérées, vivait dans le Dakota du Nord et du Sud il y a environ 66 millions d'années. L'émeu, quant à lui, se balade actuellement en Australie. De toute évidence, beaucoup de choses se sont passées entre les deux, mais on ne peut pas nier que les deux animaux auraient bien besoin d'une pédicure !
Les Vrais Protagonistes De La Catastrophe Tchernobyl Ressemblent Vraiment Aux Acteurs De La Série
La catastrophe tristement célèbre de Tchernobyl a fait la une de l'actualité internationale pendant des semaines à l'époque. Elle a depuis inspiré une minisérie très réussie de la chaîne américaine HBO et a effrayé toute une nouvelle génération. Mais à quel point la série était-elle réaliste ?
En ce qui concerne le casting des personnages, on est proches de la perfection. Les fans ont été choqués en recherchant sur Internet les véritables personnages historiques de la série et découvert que les acteurs sont tous le portrait craché des personnes historiques réelles. Ils ont tous une ressemblance frappante avec la personne qu'ils incarnent. Un excellent travail de la part d'HBO et des producteurs !
Cette Jeune Fille Et Son Arrière-grand-mère Au Même Endroit, Mais À 89 Ans D'écart
Le temps passe vite quand on s'amuse. Les enfants et les petits-enfants semblent toujours grandir si vite. Vois cette mamie et sa petite-fille au même endroit, à presque un siècle d'intervalle. C'est spécial comme photo, non ?
Les observateurs en ligne ont remarqué que les arbres ont beaucoup grandi en 89 ans. Et le monument est toujours intact, ayant survécu à la guerre et au temps. Quelles étaient les chances que cela se produise ?
La Transformation Stupéfiante En Automne D'un Érable En Seulement 11 Jours
Tu connais certainement le sirop d'érable. Les Canadiens et tout l'Amérique du Nord adorent ce sirop qui nappe avec délice les fameux pancakes. L'Amérique du Nord abrite de très nombreux érables et c'est la sève de ces arbres qui produit le délicieux sirop. monde. Outre cela et ses feuilles typiques, l'érable est aussi connu pour les couleurs magnifiques qu'il prend, une fois par an.
Les feuilles des arbres restent bien vertes pendant tout le printemps et l'été grâce à la chlorophylle, une substance vitale pour les plantes. Quand l'hiver vient, l'arbre la stocke pour l'année suivante tout en bas dans ses racines. Subitement, les feuilles se parent rapidement d'une couleur orange magnifique !
Le Terrifiant Ancien Requin Mégalodon Comparé Au Grand Blanc Moderne
Les vraies Dents de La Mer. On espère pour toi qu'il n'y aura pas de Mégalodon qui traine dans les parages pendant tes vacances à la plage, sinon tu vas te faire avaler tout cru. Heureusement pour toi, il est vieux, très, très vieux.
À l'époque des dinosaures, à peu près tout était plus grand. Les mâchoires du requin antique sont ici comparées à celles d'un Grand Blanc qui nage actuellement dans nos océans. Le contraste est vraiment saisissant. Il était trois fois plus long que le plus grand des Grands requins Blanc jamais répertorié. Et heureusement pour nous, il s'est éteint deux millions d'années avant que nous ne commencions à fouler le sol de la terre et aussi le sable des plages !
Ce Petit Bébé Trois Semaines Avant Sa Naissance Et Trois Semaines Après
Tout le monde sait d'où viennent les bébés. Du ventre de maman, bien sûr ! Le processus dure neuf mois pour fabriquer un petit humain. Que se passe-t-il à l'intérieur de l'utérus, trois semaines avant la naissance ? On a maintenant la technologie pour nous le montrer exactement.
Une maman a reçu une photo de son nouveau-né trois semaines seulement avant son arrivée lors d'une échographie de contrôle. Elle a pris une photo trop mignonne de lui avec exactement la même pose que dans l'utérus. Nous aussi on trouve ça adorable !
La Vie En Corée Du Nord Et Du Sud Ne Pourrait Pas Être Plus Différente Qu'elle Ne L'est Actuellement
On sait tous qu'il y a deux Corées à l'heure actuelle. Est-ce que tu te souviens des causes de cette grande séparation ? Pendant la guerre froide, l'Occident et les Communistes se sont battus pour contrôler le pays. Même si ce conflit est terminé ou du moins un cessez-le-feu perdure, la scission demeure. Le Nord et le Sud sont deux mondes totalement à part de nos jours !
Dans le sud, les choses sont plutôt détendues. Les citoyens aiment la musique pop, la mode et à peu près tout ce qui fait partie du monde moderne. Dans le nord ? Ce n'est pas exactement le même style de vie. Les gens vivent sans ouverture sur le monde, sans accès à Internet et avec des conditions de vie quotidienne terribles. Le monde ne voit que des photos occasionnelles de la vie dans le pays. Une différence radicale, bien au-delà de ce que l'on peut voir sur une simple photo.
La Dévastation De La Promenade De Jersey Shore Après L'Ouragan Sandy
Le Jersey Shore est récemment devenu célèbre grâce à l'émission de télé-réalité du même nom. L'endroit réel a toujours été connu et apprécié par les habitants de la côte depuis des années. En 2012, une catastrophe a frappé la plage et les conséquences ont été dévastatrices.
L'ouragan Sandy a dévasté des quartiers entiers et les dégâts subis par les entreprises et la municipalité ont été estimés à 30 milliards de dollars. Le célèbre bord de mer n'a pas été épargné et a été complètement ravagé. Quand la nature est de mauvaise humeur, on ne peut que subir les conséquences.
Christopher McCandless et l'acteur Emil Hirsch dans le film « Into The Wild »
Le livre Into the Wild a été un énorme succès en 1996. L'auteur Jon Krakauer a raconté l'histoire vraie de Christopher McCandless, un jeune diplômé d'université qui a fait de l'autostop dans une région profondément sauvage en Alaska. Inspiré par les récits de Jack London et Henry David Thoreau, il pensait que ce serait une belle aventure. Malheureusement, elle s'est tragiquement terminée !
L'acteur Emile Hirsch a en fait perdu vingt kilos pour interpréter le jeune homme qui avait renoncé à toutes ses possessions et décidé de survivre lui-même loin de la civilisation. La nourriture n'était pas abondante et les conditions étaient rudes. Christopher a perdu la vie, mais l'acteur qui l'a incarné était très convaincant à nos yeux.
Une Photo De L'arctique Il Y A Un Siècle Comparée À Aujourd'hui Qui Fait Froid Dans Le Dos
La photo a été prise à Blomstrandbreen. Où cela se situe-t-il, tu te demandes ? Nous sommes dans la région de Svalbard. Cela ne t'aide pas . Bon, c'est un groupe d'îles au large des côtes de la Norvège. Près du pôle Nord, autant dire que le temps est assez frais.
Si certains utilisateurs inquiets en ligne n'ont pas à signaler que cela démontrait les effets du réchauffement climatique, d'autres n'étaient pas d'accord. Selon un habitant, les glaciers de sa région avancent fréquemment, puis reculent. Puis, ils reviennent à nouveau ! Il diffère ainsi de nombreux autres glaciers dans le monde. Qui aurait cru ?
Une Comparaison De La Fenêtre D'un Fumeur Et Celle D'un Non-fumeur
Le tabagisme passif est un grand sujet de conversation depuis des décennies. Les personnes qui aiment fumer le font souvent tranquillement chez elles. C'est normal. Cette comparaison nous offre un regard fascinant sur deux fenêtres au fil du temps. Quand on voit ça, on imagine ce qui se passe dans nos poumons à l'intérieur de notre corps !
Étonnamment, des recherches ont révélé que les espaces de vie des fumeurs sont plutôt pollués. Les produits chimiques nocifs persistent pendant des mois, même après avoir complètement arrêté de fumer. Oups !
Un Monument Célèbre En Allemagne Avant Et Après La Réunification
Après la Seconde Guerre mondiale, l'Allemagne a connu de nombreuses difficultés. La division du pays entre les Soviétiques et l'Ouest a brisé des vies entières. La capitale elle-même était coupée en deux. Les Allemands étaient divisés en deux : l'Allemagne de l'Est et l'Allemagne de l'Ouest pendant plusieurs décennies. Lorsque le mur de Berlin est tombé en 1989, les habitants avaient beaucoup de choses à rattraper !
Sur la photo moderne, les Allemands profitent de la place devant la célèbre porte de Brandebourg. Cela peut sembler être une activité banale, mais le fait de profiter d'une journée ensoleillée ici avec des ballons était autrefois verboten. Cela signifie interdit en allemand !
Des Cousins : Un Squelette Humain Comparé À Un Squelette De Gorille
D'après les scientifiques, nous partageons presque intégralement notre ADN avec les gorilles. Vu la façon dont certaines personnes agissent de nos jours, on a envie de le croire ! Mais est-ce vraiment la réalité pure et simple ?
Pour trouver des réponses, il suffit de comparer les squelettes. Les gorilles ont 20 fois de force que n'importe quel homme fort. Leurs muscles sont tout à fait impressionnants. Mais leurs os sont aussi plus résistants et plus larges. Notre gros avantage en définitive est notre cerveau qui est beaucoup plus grand. Regarde leur petit crâne, comparé au nôtre !
Les Différences Gigantesques Entre Un Pied D'éléphant Et Un Pied Humain
Rien qu'en regardant les éléphants, on comprend tout de suite qu'ils jouent dans une autre catégorie que les humains. Une inspection plus approfondie des pieds de chaque espèce prouve que c'est vrai. Cette radiographie prouve que Dumbo marchait réellement sur la pointe des pieds !
Quelques lecteurs en ligne ont cependant contesté ce contraste. De nombreux chercheurs affirment que les chaussures ont totalement ruiné la façon dont nous sommes censés marcher. Peut-être avons-nous plus en commun avec les éléphants que l'on ne pense, malgré notre déni !
On Dit Que Les Présidents Vieillissent Rapidement Et Ce N'est Pas Un Mensonge
Tout le monde sait que les présidents prennent un sacré coup de vieux pendant leur mandat. Au début, ils ont toujours l'air frais et jeune. À la fin, c'est une histoire bien différente !
Ici, on peut voir une photo du premier discours sur l'état de l'Union du Président Obama comparée à son dernier discours en tant que président. Il est difficile de ne pas remarquer à quel point il a vieilli pendant l'exercice de ses fonctions. Cela semble être un poste stressant, et pourtant tout le monde rêve d'accéder à la Maison-Blanche !
Ce Chien Et Son Propriétaire Sont Remarquablement Similaires
Beaucoup de gens pensent que c'est vrai. De nombreux observateurs ne cessent de faire remarquer que les propriétaires ressemblent à leurs chiens et ce de manière perceptible. Ont-ils vraiment tort ?
Les psychologues ont réellement testé cette idée dans les parcs. Les études d'observation semblent montrer plus qu'une légère corrélation. Inconsciemment, il se peut que nous choisissions des animaux auxquels nous nous identifions parce qu'ils vont faire partie de la famille !
Ce Burger Avait L'air Tellement Plus Appétissant Dans La Publicité
La vérité dans la publicité n'a jamais été un point fort de l'industrie du marketing. Quand il s'agit de fast-food, la plupart des détails désagréables ne figurent jamais dans les publicités. Aujourd'hui, il semble qu'il y ait beaucoup de choses laissées de côté, du moins visuellement. C'est un peu décevant, non ?
Des chercheurs ont comparé les publicités des chaînes de restauration rapide avec leurs produits réels au fil des ans. Certains des plus grands enseignes semblaient être des récidivistes. Mais ils ne sont pas les seuls. C'est une véritable épidémie !
Des Remarquables Scans 3d Du Cerveau Humain Et De Celui Du Dauphin
La rumeur dit que les dauphins sont les Einstein de la mer. La science a à peu près démontré que c'est vrai ! Jette un coup d'œil au cerveau de Flipper à droite, côte à côte avec celui d'un humain.
Tous ces plis sont autant de marque d'intelligence, c'est sûr. Les dauphins ont un cerveau géant, tout comme les humains. Bien qu'ils ne puissent pas parler comme nous, ils communiquent quand même les uns avec les autres par des clics. Ils utilisent un super pouvoir appelé écholocation pour voir les choses en utilisant le son, en quelque sorte. Ils sont aussi très fort pour innover et résoudre les problèmes !
Avant Et Après Le Cancer
Survivre à un cancer est une réussite que l'on n'aspire jamais vraiment à décrocher, jusqu'à ce que la vie ne nous laisse plus le choix. Pour tous ceux qui ont déjoué les pronostics, il y a de quoi se réjouir. Le cancer n'est pas une promenade de santé et implique souvent des traitements intrusifs. De nombreuses personnes perdent aussi tous leurs cheveux dans le processus.
Même les enfants reçoivent parfois ce terrible diagnostic. La bonne nouvelle est que les cancers de l'enfant ont un taux de guérison élevé. Ici, un petit garçon est montré à deux étapes. D'abord, pendant la chimio. Puis, après la victoire !
Des Poumons Normaux Et Des Poumons Infectés Par La Covid-19. Les Résultats Sont Plutôt Choquants
Nous avons vécu un véritable chaos médical, mais la science commence maintenant à maîtriser le virus de la COVID-19. Tout le monde sait qu'il attaque particulièrement les poumons, dans les formes graves. Mais à quoi cela ressemble-t-il vu de l'intérieur ?
Pour l'instant, les chercheurs ont découvert que les cas extrêmes de COVID-19 produisent des cicatrices insensées sur les poumons. Ils pensent qu'elles disparaissent avec le temps et guérissent mieux que les lésions dues à la cigarette. Seul le temps nous le dira, bien sûr. À gauche, une paire de poumons normaux. À droite, ils sont infectés par la maladie !
Le Vrai Hugh Glass Et L'interprétation De Leonardo Dicaprio Dans The Revenant
The Revenant est un film primé aux Oscars dans lequel joue Leonardo DiCaprio. Dans le rôle qui lui a valu un Oscar, il incarne Hugh Glass, le célèbre trappeur américain. Les rencontres légendaires de cet homme avec des animaux et des paysages sauvages ont fait date et lui ont valu ce film !
Les aventures d'Hugh se sont évidemment déroulées avant qu'il y ait des vidéos pour capturer ses exploits. Le studio semble cependant avoir trouvé un équivalent crédible en la personne de Leo. Côte à côte, il y a vraiment une ressemblance !
Le Même Panneau De Signalisation D'un Sentier En Été Et En Hiver
Il y a ceux qui aiment la chaleur, toute l'année, mais beaucoup de personnes se réjouissent également des changements de saison et de toute l'excitation qu'ils apportent. La neige n'est pas une option négociable, pour certains !
Ici, un snowboardeur et randonneur canadien ont trouvé l'endroit idéal pour faire du sport. Le même sentier sert en été et en hiver. Le panneau prouve que son emplacement est identique !
Les Navires De Christophe Colomb Et De L'explorateur Chinois Zheng He À La Même Époque
En 1492, Christophe Colomb s'est bravement lancé sur les mers. Les cours d'histoire mentionnent le nom de ses trois navires : La Niña, la Pinta, et la Santa María. On lui accorde souvent beaucoup d'importance dans les livres d'Histoire, mais ce n'est pas comme s'il n'y avait pas d'autres explorateurs à cette époque. Qu'en est-il des marins asiatiques célèbres, par exemple ?
Il y avait Zheng He. Au cours du même siècle, il a effectué ses propres voyages d'exploration avec un bateau beaucoup plus grand, même si peu en ont entendu parler en Occident. De l'Asie du Sud-Est à l'Asie du Sud, en passant par l'Asie occidentale et même l'Afrique de l'Est, Zheng a transporté des marchandises dans le monde et combattu des pirates.
Comment Les Oiseaux Voient Réellement Les Objets Par Rapport À La Façon Dont Nous Les Voyons
Les oiseaux ont le superpouvoir de voler et personne ne peut leur enlever. Mais à quoi ressemble leur vision, là-haut dans le ciel ? Il s'avère que la science a maintenant une assez bonne réponse à cette question.
La vision est le sens le plus développé chez nos amis à plumes, apparemment. C'est comme ça qu'ils trouvent leur nourriture et leurs compagnons, après tout. Pour qu'ils puissent faire tout cela, la nature les a dotés de la capacité de voir les choses avec encore plus de couleurs que les humains. Ils peuvent voir des couleurs qui ne nous sont pas familières et que nous ne connaîtrons jamais !
Les Étoiles D'une Nuit Normale En Villes Comparées Aux Étoiles Lors D'Une Panne D'électricité
Les anciens semblaient en savoir beaucoup sur les étoiles et nous avons oublié la plupart de leurs secrets. Qu'est-ce qui se passe là-haut ? Les lumières de la ville compliquent la question parce qu'elles éclipsent les étoiles et les galaxies très, très lointaines.
Selon les enquêtes actuelles, plus de 90 % de la population en Amérique et en Europe est privée d'un ciel étoilé en ce moment. Ici, une panne d'électricité s'est produite et même si c'est l'un des pires désagréments possibles, il y a tout de même une belle surprise pour ceux qui ont levé les yeux vers le ciel !
Regarde Ce Test De La Covid Pour Le Port D'un Masque Par Rapport À L'absence De Masque
L'utilisation de masques pendant la pandémie a suscité une grande controverse. Le papier contribue-t-il vraiment à arrêter la propagation de la maladie ? Un scientifique a entrepris de prouver qu'il servait bien à quelque chose avec des photos.
La recherche consistait à demander à des gens de parler, d'éternuer, de tousser et de chanter au-dessus d'une boîte de Pétri avec et sans masque. Un jour plus tard, les bactéries ne se sont développées que d'un seul côté. Tous les virus étaient-ils également bloqués ? Difficile à dire d'après la photo, mais c'est visuellement convaincant !
La Randonneuse Cheryl Strayed Et Reese Witherspoon Qui L'incarne Dans Le Film Wild
Dans La Revanche d'une Blonde ou encore Fashion victime
, l'actrice Reese Witherspoon a certainement joué des personnages mémorables. Les femmes qu'elle incarnait étaient toujours si maniérées. Peut-être qu'elle voulait essayer quelque chose d'un peu plus naturel, pour une fois. Dans Wild, elle poursuit une aventure difficile en incarnant le personnage de Cheryl Strayed.
Dévastée par la mort de sa mère d'un cancer du poumon et par son divorce, la vraie Cheryl a entrepris un voyage de trois mois et de plus de 4 000 km, toute seule, sur le Pacifique Crest Trail, un sentier de randonnée sur la côte Ouest des États-Unis. Sans argent ni véritable entraînement, elle a survécu. Reese a raconté l'histoire dans le rôle de son sosie glamour, comme on le voit ici. Superbe casting, en effet !
L'emblématique Tour Eiffel En Photos, Hier Et Aujourd'hui
La Tour Eiffel est sans doute le monument le plus célèbre de France aujourd'hui. Beaucoup ne savent peut-être pas qu'elle était destinée à être temporaire et à exister seulement dans le cadre de l'Exposition universelle de 1889. Les gens de l'époque ont eu le bon sens de la conserver.
Côte à côte, il semble que la tour soit restée la même depuis plus d'un siècle. Mais au contraire ! Cette tour cache un secret et il est temps d'en parler. Il s'avère que chaque décennie, la tour est entièrement repeinte. Eh oui, le métal a souvent besoin d'être repeint. Qui l'aurait cru ?
Entre La Version De 1997 Et Celle De 2013, Le Jeu De Grand Theft Auto A Changé De Dimension
Grand Theft Auto a toujours été un jeu controversé depuis sa création. Les parents n'aimaient tout simplement pas toute cette violence et rien n'a vraiment changé. Tout ce qui a changé, c'est la qualité des graphismes. Maintenant, les crimes sont en HD !
Les premières versions de ce jeu ont été jouées sur Microsoft Windows, la première Playstation et la Game Boy Color à la fin des années 90. Maintenant, le jeu de courses poursuites ressemble presque à la vraie vie et est disponible sur Xbox et PS5.
Le Vrai Yossi Ghinsberg Et L'acteur Daniel Radcliffe Dans La Jungle
Bien sûr, il sera toujours connu comme Harry Potter, mais cela n'a pas empêché Daniel Radcliffe de s'essayer à d'autres rôles. Il a joué nu sur scène dans des productions théâtrales en direct. Dans ce film, il essaie de survivre en Amazonie. Il joue le rôle de Yossi Ghinsberg dans Jungle. Les fans ont-ils trouvé son interprétation crédible ?
Eh bien, elle l'était en tout cas. L'équipe des costumes a certainement bien choisi sa tenue en flanelle, en regardant de vieilles photos de la personne qu'il interprète. Daniel a aussi un air de ressemblance avec vrai Yossi. En les voyant côte à côte, c'est évident.
Une Image Satellite Avant Et Après Un Tremblement De Terre Au Japon
Chaque année, il y a environ 5 000 tremblements de terre au Japon. Heureusement, la plupart d'entre eux sont insignifiants, mais de temps en temps, un gros tremblement de terre arrive et fait des dégâts, comme on le voit ici.
En raison de sa situation géographique, le Japon ne peut pas faire grand-chose pour empêcher la terre de trembler. Ils sont juste à côté de la ceinture de feu du Pacifique, ce qui signifie qu'ils doivent faire face à non pas une, mais trois plaques tectoniques qui se déplacent quand elles le veulent. Parfois, elles sont très actives !
Les Yeux De Ce Chaton Pendant Le Jour Et Pendant La Nuit
Bien sûr, les chiens sont les meilleurs amis de l'homme, mais il y a quand même un avantage à être un chat. La nuit, tu as une vision extrêmement puissante ! C'est très pratique pour chasser.
Lorsque leurs pupilles se dilatent, leurs yeux passent à la vitesse supérieure. Méfiez-vous amis souris : On n'échappe pas à un chaton déterminé qui rôde. C'est intrigant de regarder ces changements en voyant les photos des yeux côte à côte !
La Vraie Tami Oldham Et L'actrice Shailene Woodley Dans À La Dérive
Tami Oldham est la personne qui a inspiré le film À La Dérive. Les fans du film n'arrivent pas à croire qu'elle ait survécu en pleine mer. Après un ouragan, il n'y a pas beaucoup de bateaux qui flottent encore à la verticale !
.
.
Tami Oldham a survécu pour raconter le récit de son voyage épique dérivant dans le Pacifique. Pour le film, l'actrice Shailene Woodley convenait parfaitement au rôle. Cela semble être un bon choix, en les voyant côte à côte maintenant. Que dis-tu ?
Les Joueuses De Basket-ball Dominent Légèrement Les Pom-pom Girls
Les enfants du monde entier rêvent de rejoindre un jour la NBA ou la WNBA. C'est un rêve difficile à réaliser, mais il faut croire en ses chances. La taille est un facteur important bien sûr et il n'y a aucun moyen d'y couper !
Mais quand il s'agit de pom-pom girls, la taille n'est pas vraiment l'exigence principale. Elles sont de toutes les statures. Ici, l'équipe de basketteuses et les pom-pom girls posent ensemble. Tout un contraste !
Le Pianiste Don Shirley Et Son Interprète L'acteur Mahershala Ali Dans Green Book : Sur Les Routes Du Sud
Le monde connaît Mozart depuis toujours, mais il n'est pas le seul à avoir maîtrisé les touches noires et blanches du piano. Les cinéphiles ont adoré découvrir la vie du prodige du piano Donald Shirley dans le film Green Book. L'acteur Mahershala Ali l'a-t-il joué de façon convaincante ?
De toute évidence, il l'a fait. Mahershala Ali a même remporté l'Oscar du meilleur acteur dans un second rôle pour ce film et les fans étaient aux anges. En les voyant ainsi ensemble, on trouve qu'il y a aussi une ressemblance assez forte !
Le Bonheur Du Chien À La Plage Comparé Au Moment Où On Lui Nettoie Ses Petites Pattes Après
Se défouler dans le sable et les embruns n'est pas seulement une partie de plaisir pour les gens. Les chiens aiment ça tout autant et le bonheur se lit sur leur visage. Ils font plaisir à voir.
Mais qu'en est-il lorsque la fête est terminée ? Eh bien, il faut passer pas la case nettoyage. Qu'ils le veuillent ou non, une grande quantité de sable reste coincée dans leurs pattes. Ne t'inquiète pas, gentil toutou. Les douches ne durent pas éternellement.